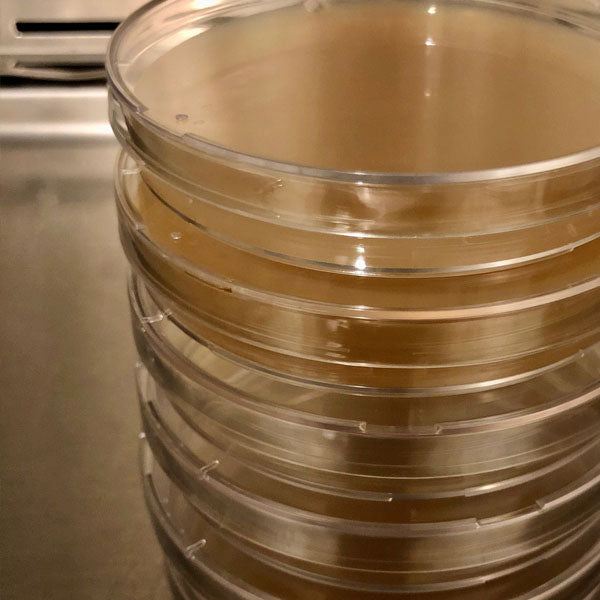
Malt Extract Agar Plates - 20 count

Malt Extract Agar Plates - 20 count
Malt Extract Agar Plates - 20 count
Regular price
$40.00
Regular price
Sale price
$40.00
Unit price
per
Couldn't load pickup availability
20 pre-poured malt extract agar plates.
View full details